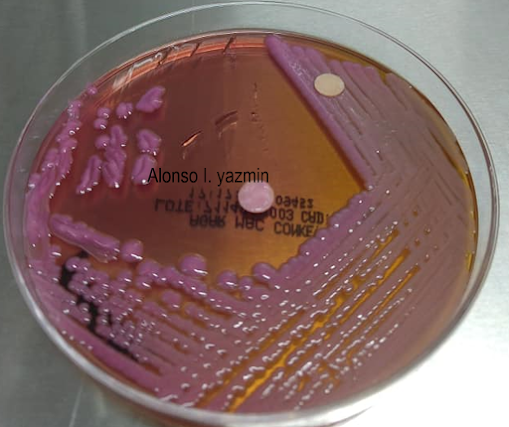

Los bacilos
no fermentadores o NFBs, ya que presentan forma bacilar, son Gram negativos y
no tienen la capacidad de fermentar la glucosa.
Dentro de los
NFBs sobresale por su importancia el género Pseudomonas, con base
en estudios de la homología de RNA se integra por más de 30 especies. Como
resultado de estudios que incluyen el análisis de hibridación de DNA-rRNA, la
hibridaciónDNA-DNA y la secuenciación del rRNA 16S se redefinió el género Pseudomonas,
proponiendo la ampliación a 10 géneros, 3 de los cuales presentan especies de
importancia médica como son Pseudomonas, Burkholderia y Stenotrophomonas; en lo
que se refiere a las especies de Pseudomonas de interés médico están
P.aeruginosa,
P.fluorescens, P.putida, P.stutzeri y P.alcaligenes.
Pseudomonas
aeruginosa es un bacilo Gram negativo de 2-5 micras de largo por una micra de
ancho, con un metabolismo aerobio estricto, aunque puede crecer en ausencia del
oxígeno cuando en el medio se presentan nitratos o arginina. Es móvil por un flagelo
polar, utiliza la glucosa y otras fuentes carbonadas por vía oxidativa. Esta bacteria
se considera versátil nutricionalmente, pudiendo crecer en fuentes nutritivas
muy simples e incluso utilizar lentamente compuestos empleados en la formulación
de desinfectantes y antisépticos. Se considera mesofílica, aunque puede crecer
a 42 grados, se considera de fácil crecimiento, por lo que puede ser recuperada
en medios simples, ricos y selectivos.
La
patogenicidad de P.aeruginosa se explica por lo complejo de su estructura celular
y a una serie de productos que excreta, lo que le confiere capacidad invasiva y
toxigénica. Aunado a lo anterior, participa su adaptabilidad al medio ambiente,
lo que al fin de cuentas conlleva al establecimiento de una infección local o
sistémica. Así, los factores asociados a la virulencia de P.aeruginosa que
reconocemos actualmente son: resistencia a los antibióticos y agentes químicos,
pilis, exoenzimas, mucoexopolisacarido y endotoxinas.
P.aeruginosa
es la especie del grupo de BNFs que más frecuentemente se asocia con
infecciones en el humano, y estas pueden ser: Infecciones comunitarias como
foliculitis, infecciones de oídos, infecciones de ojos, neumonía en pacientes
con fibrosis quística y endocarditis.
Infecciones
intrahospitalarias como Neumonía, abscesos en heridas, bacteriemia, infección
de piel quemada y en aparato urinario.
Pruebas bioquímicas para la identificación de Pseudomonas aeruginosa
Pruebas bioquímicas para la identificación de Pseudomonas aeruginosa
Crecimiento de Pseudomonas sp. en agar Múeller-Hinton
Crecimiento de Pseudomonas sp. en agar Mac Conkey
Crecimiento de Pseudomonas aeruginosa en agar Sangre
Crecimiento de Pseudomonas aeruginosa en agar CLED
Crecimiento de Pseudomonas aeruginosa en agar Mac Conkey
Crecimiento de Pseudomonas aeruginosa en agar Müeller Hinton
Citas bibliográficas:
Recomendaciones para la selección de antimicrobianos en el estudio de sensibilidad
in vitro con sistemas automáticos y semiautomáticos GEMARA- MENSURA